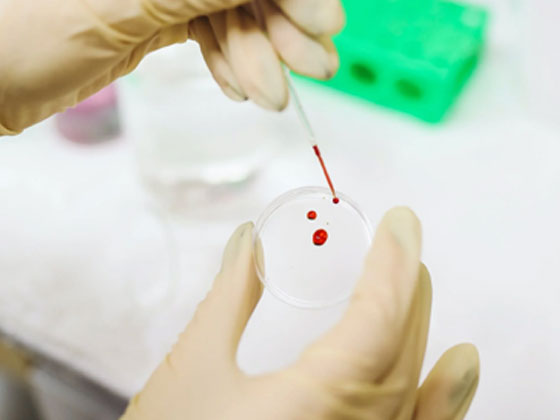

服 務(wù) 項(xiàng) 目
Service Items
關(guān)注我們
010- 67864643
18519117333/18911082399
zyyj0303@163.com
北京市經(jīng)濟(jì)技術(shù)開發(fā)區(qū)經(jīng)海四路25號(hào)院
2號(hào)樓2單元102室、402室
本公司設(shè)有綜合辦公室、檢測室、技術(shù)部和質(zhì)量部等。是專業(yè)從事醫(yī)學(xué)研究和試驗(yàn)發(fā)展和環(huán)境檢測為主的檢測服務(wù)型機(jī)構(gòu)。包含:血液、尿液、毛發(fā)等生物檢材中的毒物(藥理)檢測、生活飲用水檢測、廢水檢測、廢氣檢測、噪聲檢測等
檢測范圍
毒品、尿液、毛發(fā)等生物檢材檢測項(xiàng)目
? 氣體毒物如一氧化碳、天然氣、硫化氫和工業(yè)廢氣等檢測標(biāo)準(zhǔn)
? 《生物檢材中嗎啡、O6-單乙酰嗎啡和可待因的檢驗(yàn)方法 》(SF/T 0114-2021)我們承諾將永遠(yuǎn)保護(hù)您的個(gè)人信息安全,絕不泄露您所填寫的信息